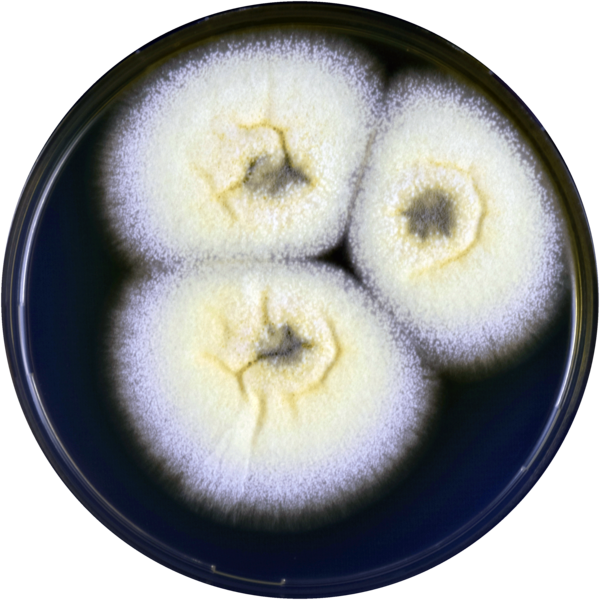

Penicillium paradoxum
Penicillium paradoxum (лат.) — вид грибов-аскомицетов, входящий в род Пеницилл (Penicillium) семейства Aspergillaceae.
Первоначально был описан Дороти Феннелл и Кеннетом Рапером в 1955 году как Aspergillus paradoxus из-за конидиального аппарата, напоминающего аспергиллы. Позднее телеоморфная стадия была выделена в род Hemicarpenteles. В 2014 году на основании филогенетических исследований вид был перенесён в род Penicillium.
Общие сведения
| Penicillium paradoxum | |
|---|---|
| Научная классификация | |
|
Домен: Царство: Подцарство: Отдел: Подотдел: Класс: Подкласс: Порядок: Семейство: Род: Подрод: Секция: Вид: Penicillium paradoxum |
|
| Международное научное название | |
| Penicillium paradoxum (Fennell & Raper) Samson, Houbraken, Visagie & Frisvad, 2014[1] | |
| Синонимы | |
| Номенклатурный тип | |
|
IMI 061446 (неотип)[2] |
Описание
Колонии на агаре Чапека широко-растущие, на 10—14-е сутки достигающие диаметра в 7—8 см, шерстистые, светло-жёлтые. Спороношение ограниченное до довольного обильного, в светло-сине-зелёных тонах. Реверс колоний ярко-жёлто-оранжевый, в среду выделяется жёлто-оранжевый пигмент. Экссудат нередко довольно обильный, в виде жёлтых капелек. Запах очень сильный, резкий, неприятный[4].
Клейстотеции образуются в больших количествах, сначала напоминают мягкие склероции, затем становятся жёсткими, созревают на 25—30-е сутки, сначала белые, затем бежевые или винно-бежевые, шаровидные, 200—400 мкм в диаметре. Окружены сетью разветвлённых гиф и 2—3 слоями утолщённых клеток. Аски восьмиспоровые, 8—10 × 7—8 мкм. Аскоспоры линзовидные, гладкостенные, с двумя параллельными экваториальными гребнями, 4,5—5,5 × 3—3,5 мкм.
На агаре с солодовым экстрактом (MEA) колонии также широко и быстро-растущие, пигментированные менее ярко, чем на агаре Чапека. Клейстотеции более обильные.
Конидиеносцы фототропичные[4], от 1—2 мм до 1 см длиной, гладкостенные, 12—20 мкм толщиной, на верхушке несут отчётливое вздутие (везикулу) 15—25 мкм в диаметре, на котором располагаются фиалиды, что придаёт им сходство с конидиеносцами рода Aspergillus[4]. Фиалиды размером 10—12 × 3,5—5,5 мкм; шейка краевых фиалид часто загнутая к центральным, вследствие чего цепочки конидий могут образовывать колонки. Конидии яйцевидные, мелкошиповатые, 5,5—6,5 × 4—5 мкм.
Экология
Копрофильный гриб, встречается редко. Преимущественно выделяется с экскрементов животных[5]. Впервые был выделен в 1948 году в Веллингтоне (Новая Зеландия) из помёта опоссума[6]. Помимо Новой Зеландии, вид был обнаружен в Англии, Индии[6] и Чехии (в 2018 году в регионе Кршивоклатско)[7].
Также гриб был обнаружен в почве в Индии[5] и выделен в качестве эндофита из лекарственного растения Coleus forskohlii[8].
Охранный статус
Вид не внесён в Красный список МСОП и не имеет официально определённого охранного статуса. В некоторых источниках, в частности в базе данных «The Recently Extinct Plants and Animals Database», имеет статус «Переоткрытый» (англ. Rediscovered)[9], поскольку после длительного периода без находок был вновь обнаружен в штате Махараштра (Индия) в 2016 году. Данный статус не является формальной оценкой угроз существованию вида по критериям МСОП.
Таксономия
Penicillium paradoxum (Fennell & Raper) Samson, Houbraken, Visagie & Frisvad, Stud. Mycol. 78: 352 (2014). — Aspergillus paradoxus Fennell & Raper, Mycologia 47 (1): 69 (1955).
Неотип — IMI 061446.
- Aspergillus ingratus Yaguchi et al., 1993
- Aspergillus paradoxus Fennell & Raper, 1955
- Hemicarpenteles paradoxum A.K.Sarbhoy & Elphick, 1968
Примечания
Литература
- Fennell D. I., Raper K. B. New species and varieties of Aspergillus // Mycologia. — 1955. — Vol. 47 (1). — P. 68—89.
- Rajeshkumar K. C., Marathe S. D., Lad S. S. et al. Rediscovery of Penicillium paradoxum (Ascomycete: Aspergillaceae) from Maharashftra, India // Journal of Threatened Taxa. — 2016. — Vol. 8 (6). — P. 8919—8922. — doi:10.11609/jott.2569.8.6.8919-8922.
- Sarbhoy A. K., Elphick J. J. Hemicarpenteles paradoxus gen. et sp.nov.: The perfect state of Aspergillus paradoxus // Transactions of the British Mycological Society. — 1968. — Vol. 51 (1). — P. 155—157.
- Visagie C. M., Houbraken J., Frisvad J. C. et al. Identification and nomenclature of the genus Penicillium // Studies in Mycology. — 2014. — Vol. 78. — P. 343—371. — doi:10.1016/j.simyco.2014.09.001.